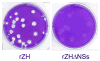
Fig. 5

Reverse genetics technology for Rift Valley fever virus: current and future applications for the development of therapeutics and vaccines
- PMID: 19682499
- PMCID: PMC2801414
- DOI: 10.1016/j.antiviral.2009.08.002
Reverse genetics technology for Rift Valley fever virus: current and future applications for the development of therapeutics and vaccines
Abstract
The advent of reverse genetics technology has revolutionized the study of RNA viruses, making it possible to manipulate their genomes and evaluate the effects of these changes on their biology and pathogenesis. The fundamental insights gleaned from reverse genetics-based studies over the last several years provide a new momentum for the development of designed therapies for the control and prevention of these viral pathogens. This review summarizes the successes and stumbling blocks in the development of reverse genetics technologies for Rift Valley fever virus and their application to the further dissection of its pathogenesis and the design of new therapeutics and safe and effective vaccines.
Figures

References
-
- Abd el-Rahim IH, Abd el-Hakim U, Hussein M. An epizootic of Rift Valley fever in Egypt in 1997. Rev Sci Tech. 1999;18:741–8. - PubMed
-
- Abdel-Motal UM, Gillis J, Manson K, Wyand M, Montefiori D, Stefano-Cole K, Montelaro RC, Altman JD, Johnson RP. Kinetics of expansion of SIV Gag-specific CD8+ T lymphocytes following challenge of vaccinated macaques. Virology. 2005;333:226–38. - PubMed
-
- Abdel-Motal UM, Wigglesworth K, Galili U. Mechanism for increased immunogenicity of vaccines that form in vivo immune complexes with the natural anti-Gal antibody. Vaccine. 2009;27:3072–82. - PubMed
Publication types
MeSH terms
Substances
Grants and funding
LinkOut - more resources
Full Text Sources
Other Literature Sources

